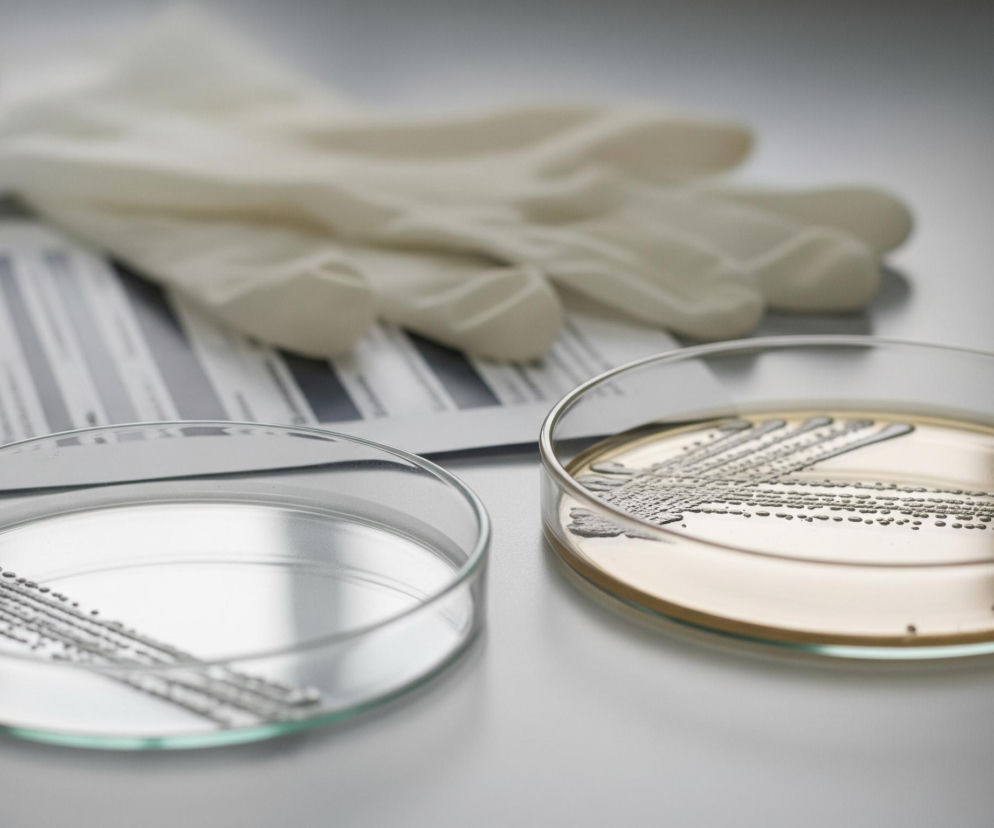
Na pierwszym planie, po prawej stronie, znajduje się szalka Petriego z bursztynowym podłożem, na którym rosną liczne, ciemnoszare kolonie drobnoustrojów ułożone w równoległe, faliste linie oraz rozsiane kropki. Po lewej stronie leży druga, pusta szalka Petriego, a na jej przezroczystym dnie widoczne są podobne ciemnoszare smugi. Tło obrazu jest rozmyte; w górnej części widać złożone, jasne rękawiczki ochronne leżące na kartce papieru z wydrukowanymi pionowymi, czarnymi liniami i fragmentami tekstu. Całość kompozycji utrzymana jest w chłodnych odcieniach szarości i bieli, z ciepłym akcentem bursztynowego podłoża.

Spis treści
Nowe podejście do antybiotyków
Specjaliści z lubelskiej Kliniki Okulistyki Ogólnej i Dziecięcej USK1 w Lublinie opracowali nowatorskie rekomendacje dotyczące stosowania antybiotyków. Celem tych wytycznych jest skuteczne przeciwdziałanie rozwojowi antybiotykooporności drobnoustrojów, szczególnie w kontekście leczenia pooperacyjnego. Problem narastającej oporności bakterii na dostępne antybiotyki jest jednym z kluczowych wyzwań współczesnej medycyny na całym świecie.
Opracowane przez lubelskich okulistów wytyczne mają na celu zmianę dotychczasowych praktyk w podawaniu leków po zabiegach okulistycznych. Kluczowym aspektem jest wprowadzenie intensywnej, lecz krótkotrwałej terapii antybiotykowej, która ma minimalizować ryzyko powstawania opornych szczepów bakterii. To podejście stanowi znaczący krok w kierunku poprawy bezpieczeństwa pacjentów i efektywności leczenia.
"- My również przeciwdziałamy tworzeniu się antybiotykooporności poprzez leczenie naszych chorych w sposób intensywny, ale krótki. Krótki, czyli 7 dni. Intensywny cztery razy dziennie. Myślę tu o podawaniu antybiotyków w kroplach po operacji na przykład zaćmy. Podstawowym błędem, który jeszcze wciąż w wielu krajach jest obecny, to na przykład stopniowe odstawianie antybiotyków przez kilka tygodni i terapia długotrwała. Tak się nie powinno robić, ponieważ indukuje się powstanie antybiotykooporności drobnoustrojów - mówi prof. Robert Rejdak, szef lubelskiej Kliniki Okulistyki Ogólnej i Dziecięcej USK1 w Lublinie."
Jak wygląda nowa terapia?
Profesor Robert Rejdak, który kieruje lubelską Kliniką Okulistyki Ogólnej i Dziecięcej USK1 w Lublinie, szczegółowo opisał zasady nowego podejścia. Podkreślił, że leczenie powinno być zarówno intensywne, jak i krótkotrwałe, idealnie trwające siedem dni. Terapia polega na podawaniu antybiotyków w kroplach cztery razy dziennie, co jest szczególnie istotne po operacjach, takich jak zabieg usunięcia zaćmy.
Profesor Rejdak wskazał również na powszechny błąd, nadal praktykowany w wielu krajach, którym jest stopniowe odstawianie antybiotyków przez okres kilku tygodni. Długotrwała terapia, w przeciwieństwie do rekomendowanej, krótkiej i intensywnej, nie tylko jest nieefektywna, ale przede wszystkim indukuje powstawanie antybiotykooporności drobnoustrojów. Takie praktyki należy bezwzględnie unikać, aby nie przyczyniać się do narastania globalnego problemu zdrowotnego.
Międzynarodowa współpraca medyczna
W procesie tworzenia tych przełomowych rekomendacji aktywnie uczestniczyli nie tylko lubelscy okuliści, ale także zespół doświadczonych lekarzy z innych krajów Europy Środkowej. Ta międzynarodowa współpraca naukowo-medyczna zaowocowała powstaniem kompleksowego dokumentu, który może mieć globalny wpływ na praktykę kliniczną w okulistyce. Zaangażowanie ekspertów z różnych regionów pozwoliło na stworzenie zaleceń o szerokim zastosowaniu.
Rezultaty pracy lubelskich okulistów i ich współpracowników zostały opublikowane w prestiżowym piśmie naukowym „Antibiotics”. To potwierdza rangę i wiarygodność opracowanych wytycznych, czyniąc je cennym źródłem wiedzy dla środowiska medycznego. Publikacja w tak renomowanym czasopiśmie jest świadectwem wysokiej jakości badań i ich potencjalnego wpływu na światową medycynę.
Gdzie będą wprowadzane rekomendacje?
Opracowane w Lublinie rekomendacje dotyczące przeciwdziałania antybiotykooporności są już przygotowywane do wdrożenia. Planuje się, że znajdą one zastosowanie nie tylko w Polsce, ale również w wielu innych krajach europejskich. To świadczy o uniwersalnym charakterze i znaczeniu tych wytycznych dla globalnego zdrowia publicznego. Szerokie rozpowszechnienie zaleceń ma kluczowe znaczenie dla walki z opornością.
Wprowadzanie tych zaleceń nie ograniczy się jedynie do Europy. Istnieją plany, aby lubelskie rekomendacje były stosowane także na innych kontynentach. To pokazuje globalny zasięg i potencjał wpływu polskiej medycyny na światowe standardy leczenia okulistycznego. Dzięki temu osiągnięciu, metody zapobiegania antybiotykooporności mają szansę stać się globalnym standardem.
Artykuł i zdjęcie wygenerowane przez sztuczną inteligencję (AI). Pamiętaj, że sztuczna inteligencja może popełniać błędy! Sprawdź ważne informacje. Jeżeli widzisz błąd, daj nam znać.